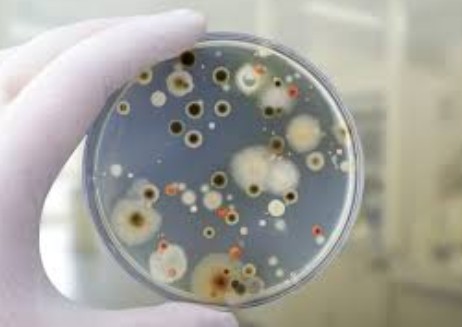

Vos greens méritent des soins personnalisés
Le Diagnostic Microbiologique est La Solution !
Les bactéries et les champignons colonisent tous les écosystèmes terrestres. Les sols minéraux des terrains de
sport (golf, rugby, foot, etc.) combinés aux traitements chimiques (phytosanitaires et engrais) appauvrissent
drastiquement cette vie microbienne. Les communautés microbiennes « positives » demeurent essentielles
au gazon par leurs nombreux avantages :
- stimulation de la croissance des racines ;
- libération d’éléments fertilisants ;
- détoxification ;
- antagonisme vis-à-vis de pathogènes ;
- occupation spatiale de la niche écologique, etc.
Ces communautés diminuent significativement les besoins en eau, en engrais et en fongicides de vos greens. (Schéma n°1) :

Schéma 1 – Vie microbienne bénéfique
Diagnostiquer précisément l’état biologique du sol permet d’adapter les traitements et d’éviter les résultats aléatoires.
Depuis la Loi Labbé, les jardiniers adoptent des produits biologiques intégrant des micro-organismes pour remplacer les intrants chimiques. Ces formulations produisent des résultats variables car elles sont appliquées sans diagnostic préalable. Parce que chaque parcours est unique, Biophytech personnalise la redynamisation de vos sols en s’appuyant sur la richesse de vos propres microbiomes.
1 . Diagnostic Biologique : les 3 Indicateurs Clés du Sol de Golf
Les bases de l’analyse du fonctionnement microbiologique d’un sol peuvent se résumer en 3 indicateurs majeurs à prendre en compte :
BIOPHYTECH - Indicateurs d'Analyse
| INDICATEURS | CARACTÉRISTIQUES |
|---|---|
| BM - Biomasse Microbienne | Nombre et type de micro-organismes |
| IAM - Indice d'Activité Microbienne | États physiologiques : morts, endormis ou performants |
| MO - Taux & Type de Matière Organique | Carbone disponible pour les micro-organismes |

Schéma 2 – Biomasse microbienne

Schéma 3 – Carbone labile : Carburant du sol
Les trois compartiments (photo 1) (Sol, Eaux et Plante) doivent être analysés.
Le sol (schéma 4), lui nécessite le prélèvement d’au moins 3 profondeurs (horizons).

Photo 1 – Carotte du sol de Green

Schéma 4 – Cycle de l’eau
2 . Méthodes d’Analyse du Microbiome | Protocoles & Techniques de Mesure
Chaque type d’analyse utilise des méthodes spécifiques détaillées comme suit :
BIOPHYTECH - Analyse Microbienne des Sols
| MESURES | MÉTHODES | INDICATEURS |
|---|---|---|
|
|
|
|
|
|
|
|
|

Photo 2 – Culture en Boite de pétri & caractérisation au microscope
(1) Ratio Pathogène / Bénéfique – 3 méthodes de quantification (photo 2)
- en Nombre : par comptage du nombre d’Unités Formant des Colonies par gramme sec de sol ;
- en Abondance : la quantité de spores + mycélium via le taux de carbone microbien ;
- en Qualité : par observation sur milieux de culture pour caractériser le type de micro-organisme (neutres, bons et mauvais).
(2) Ratio Champignons / Bactéries – 2 méthodes de quantification
- par Comptage au microscope par des méthodes de colorations spécifiques (morte ou vivantes) ;
- par Quantification moléculaire de l’ADN fongique (18S) et microbien (16S).
(3) Dynamiques des populations (shcéma 5)
- Évolutions dans le temps et à différentes profondeurs
(4) Types d’activités physiologiques
- Analyse de la respiration via le dégagement de CO2 grâce à un capteur analyseur ;
- Mesure des activités enzymatiques (chitinase, cellulase, phytase, oxydo-réductase, etc.).
(5) Taux de Carbone Labile – 2 méthodes de quantification
- pour le Carbone labile : basé sur la réduction d’une solution de permanganate de potassium
- pour les Matières Organiques (MO) liées aux minéraux ou libres : par mesure de carbone microbien.

Schéma 5 – Cycle du Pathogène
3 . Interprétation des Résultats | Comprendre les Ratios & Activités Microbiennes
A –
Les Types et Ratios Microbiens
Analyse de : Nombre, Abondance & Qualité
Photo 3 – Développement de la vie microbienne
Révèle le « complexe parasitaire » et les pathogènes parfois invisibles agronomiquement

Schéma 6 – % de spores de champignons germés

Schéma 7 – Rapport Champignons / Bactéries
L’analyse des ratios
Champignons / Bactéries
Détermine le taux d’aération du sol et des risques de feutre ou black-layer
Pathogènes / Antagonistes
Détermine les risques de maladie

Schéma 8 – Rapport Pathogènes / Antagonistes
B –
Les Types d’activités physiologiques
Quantifie les capacités enzymatiques au service du gazon :
- dégradation des sclérotes (dollar spot, rhizoctonia, etc.) par les (chitinases, cellulases) (schéma 8)
- libération des éléments phosphorés ou azotés issus de la matière organique (phytases)
- transformation de peptides en hormones (auxines) d’élongation racinaire

Schéma 9
C –
Le Type de MO & le Taux de Carbone labile
Mesure l’adéquation du réservoir énergétique pour la multiplication des populations positives.
Les MO stables (lignine, fibres) auront tendance à agir sur la structure physique du sol notamment en donnant accès à l’oxygène aux microbes, alors que la M.O. labile (cellulose, acides aminés ou humiques) leur fourniront rapidement la source de carbone nécessaire à leur multiplication.

Schéma 10 – Cycle du Pathogène
D –
La Dynamique des populations dans le temps
L’homogénéité des sols de greens (contrairement aux sols agricoles diversifiés) offre un référentiel précis pour mesurer l’évolution des populations microbiennes.
Le suivi quantifie soit l’élimination des pathogènes, soit la stimulation des populations antagonistes, fertilisantes et stimulantes, révélant trois états : Sol Résilient, Sol Dynamique et Sol Sensible.

Schéma 11 – Évolution théorique des populations en Trichoderma
4 . SRecommandations pour l’entretien des Greens
Le risque phytopathologique apparaît quand
- Les pathogènes dominent les antagonistes en nombre et en activité
- Les conditions aérobies ou anaérobies favorisent leur développement
- Les graminées présentent un état physiologique affaibli.

Schéma 12

Le Ratio Champignons / Bactéries se situe idéalement entre 1 et 5 %. En deçà, la dominance bactérienne traduit une anaérobie du milieu nécessitant une intervention mécanique pour réoxygéner le sol. Les horizons de surface présentent un taux et une diversité de matières organiques (MO) 2 à 3 fois supérieurs aux horizons profonds.
Le taux de carbone labile (exprimé en µg de C/g sec de terre) varie selon le type de green : 2 fois inférieur dans les greens sables comparés aux greens terre, et 5 fois inférieur aux fairways. Les espèces influencent fortement cette production : les greens d’Agrostide génèrent deux fois plus de carbone labile que les ray-grass ou fétuques.

Schéma 13 – Taux de Carbone Labile
Le secret d’une revitalisation microbienne réussi ? Votre Trichodynamisation !
Elle s’obtient grâce à toutes ces analyses biologiques et leurs résultats chiffrés.
Ignorez-vous encore l’état du microbiome de vos greens ?
Vos greens, départs et fairways méritent plus qu’un traitement standardisé. Ils méritent un diagnostic qui démultiplie vos résultats.
